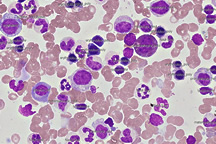

- 2026/06/07
- Cu-Cyto ver1.3.0を公開しました
- 2022/07/05
- Cu-Cyto ver1.1.5を公開しました
- 2018/06/20
- 中部経済新聞でCu-Cytoが紹介されました。
- 2018/05/28
- ホームページを公開いたしました。
-

- PD-L1
- PD-L1 発現のスコアリング

-

- Lymph node
- リンパ節への
- 癌の転移をマーキング
-

- BALF
- BALFの細胞分画集計
-
- Bone marrow
- 骨髄の血液系細胞の分類と集計
※Cu-Cyto は医療機器ではありません。
国際特許出願中










